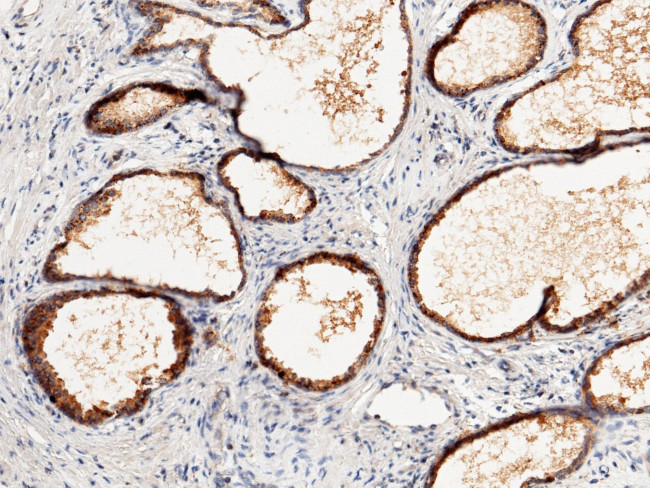
SIAE Antibody in Immunohistochemistry (Paraffin) (IHC (P))

Search
Invitrogen
SIAE Polyclonal Antibody
{{$productOrderCtrl.translations['antibody.pdp.commerceCard.promotion.promotions']}}
{{$productOrderCtrl.translations['antibody.pdp.commerceCard.promotion.viewpromo']}}
{{$productOrderCtrl.translations['antibody.pdp.commerceCard.promotion.promocode']}}: {{promo.promoCode}} {{promo.promoTitle}} {{promo.promoDescription}}. {{$productOrderCtrl.translations['antibody.pdp.commerceCard.promotion.learnmore']}}
产品信息
PA5-81021
宿主/亚型
分类
类型
抗原
偶联物
形式
浓度
规格
保存条件
运输条件
RRID
产品详细信息
This product is preservative free. It is recommended to add sodium azide to avoid contamination (final concentration 0.05%-0.1%).
This antibody has specificity for Human SIAE/AIS6.
靶标信息
This gene encodes an enzyme which removes 9-O-acetylation modifications from sialic acids. Mutations in this gene are associated with susceptibility to autoimmune disease 6. Multiple transcript variants encoding different isoforms, found either in the cytosol or in the lysosome, have been found for this gene.
仅用于科研。不用于诊断过程。未经明确授权不得转售。